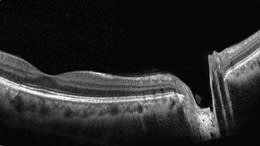

OCT on the Rise
New anterior segment applications and greater patient need are fueling growth – even in general practices.
BY RENÉ LUTHE SENIOR ASSOCIATE EDITOR
When asked for the secret of his success, hockey legend Wayne Gretzky famously replied, "I skate to where the puck is going to be, not where it has been." You don't have to be a Hall of Famer to heed the Great One's advice. Even savvy medical practices can do the same. More and more ophthalmologists who analyze the demographic trends in eye care and the technology road maps of diagnostic instrument manufacturers see optical coherence tomography as an integral part of ophthalmology practice in the near future — capable of imaging both anterior and posterior structures with exquisite precision — and they're positioning themselves now to be ready when the puck arrives in the form of a surge in patient need.
The American Academy of Ophthalmology recently estimated that by 2020, 43 million Americans will suffer from age-related eye diseases, compared with 28 million today. That 54% increase in one decade surely won't be matched by commensurate growth in the ranks of ophthalmic subspecialists, so more of the caseload in retina and glaucoma will move to general practices, at least for initial workups and comanagement of textbook cases. Couple that with the recent explosion in OCT development that adds cataract, glaucoma and refractive applications, and these devices — once the exclusive domain of retina specialists and academic institutions — are becoming versatile enough for even general ophthalmologists to consider.
Yet for many, it is a case of supremely bad timing, with these new technologies being launched during the worst economic crisis since the Great Depression of the 1930s. Reluctance to invest is the typical first reaction. But don't forget that iconic skyscrapers like the Empire State Building and the Chrysler Building were erected during the Depression by visionaries who prepared for the inevitable turnaround in the economy and positioned themselves to capitalize on it. You can, too.

MAIN IMAGE ADAPTED FROM RETINAL OCT; DIGITAL ILLUSTRATION BY JOEL & SHARON HARRIS. INSET IMAGES DEPICT POST-LASIK CORNEA (TOP) AND NARROW ANGLE (BOTTOM), COURTESY OF DAVID HUANG, MD, DOHENY EYE INSTITUTE, LOS ANGELES.
Baby Boom = OCT Boom
With the Baby Boomers continuing their inexorable march toward old age, and the ocular diseases that go with it, general ophthalmologists can expect to encounter problems like glaucoma and AMD more frequently. According to a report by the National Eye Institute, while approximately one million Americans over the age of 40 are now blind and about 22.4 million more are visually impaired, those numbers are expected to double over the next 30 years due to diseases such as diabetic retinopathy, age-related macular degeneration, glaucoma and cataract. OCT users interviewed here claim the technology can help you better care for, and keep, those patients. "My device enables me to do exquisitely wonderful things for glaucoma and macular diseases," says Michael Korenfeld, M.D., of Washington, Mo.
• Macular applications. Philip Paden, M.D., of Medford, Ore., is a general ophthalmologist "with a serious interest in medical retina as it relates to diabetes." He says that incorporation of OCT "was instrumental in becoming a full-service medical retina practice." OCT enabled him to find 52 new wet AMD patients in the first year he had the system. These patients return for care every 4 to 8 weeks.
"When a wet AMD patient presents initially, he or she gets a fluorescein angiogram and a high-resolution OCT," he explains. "Then we treat with Avastin and dexamethasone injections and follow the patient." Although some practitioners repeat FA monthly, he says, OCT can eliminate the need for that. "The OCT is so good and provides highly reproducible retinal thickness measurements that we guide our ongoing treatment based on OCT and rarely if ever repeat the fluorescein angiogram." Image registration and eye tracking ensure reproducibility, he says.
J. Isaac Barthelow, M.D., of North Valley Eye in Chico, Calif., describes his practice as general ophthalmology. They see between 50 and 70 patients per day. He estimates the practice performs 5 to 10 OCTs each day for macular pathologies including AMD, diabetic macular edema and epiretinal membranes, as well as for glaucoma and cataract indications. His OCT system, he says, allows him to provide intravitreal injections to his AMD patients as well.
Dr. Barthelow believes that OCT also helps with patient compliance and education. "In my OCT room, I have examples of normal eyes and various pathologies such as wet and dry AMD, diabetes, etc. I show my patients the changes in their own eyes and use the examples to educate them on what can happen. It's very powerful and makes a huge impression. This leads to increases in compliance with their treatment regimen," he says.
• Glaucoma applications. David Huang, M.D., Ph.D., associate professor at the University of Southern California and chairman of the Advanced Imaging for Glaucoma study (www.AIGStudy.net), says OCT is a valuable tool for glaucoma diagnosis. "It enables you to see the nerve fiber layer, which you cannot see very well on ophthalmoscopy," he points out, describing it as a more sensitive way of detecting glaucoma than other advanced imaging or digital imaging techniques, especially given the ability to measure ganglion cell complex thickness in the macula. "By looking at the ganglion cells, the nerve fibers, the disc, you just have a lot of information about anatomy that helps you in diagnosing those early, borderline glaucoma cases and managing ocular hypertension."
Dr. Korenfeld agrees concerning OCT's value for glaucoma management. "You learn so much information that you cannot get any other way. We run our OCT all day."
• Premium IOL Considerations. OCT can be a real lifesaver for cataract surgeons who implant a lot of premium IOLs, according to Dr. Barthelow. He calls it "an integral part of my preoperative work-up." Patients with epiretinal membranes, any sort of macular pathology that reduces contrast sensitivity, or the likelihood of a vitrectomy procedure in the future all are contraindicated for premium IOLs, he says.
Those presentations can be quite subtle. "It's amazing what I find on the OCT," he says. In some cases, OCT results dissuade him from recommending a premium IOL. "That's better for the patient and decreases the amount of counseling I would have to do later had I put in a premium lens and results were subpar." Conversely, he says, he has had patients for whom OCT screening gave him the confidence to implant a premium IOL, when he was initially hesitant.
• Refractive applications. In addition to being useful in screening refractive surgery candidates for keratoconus, Dr. Huang, director of the Doheny Laser Vision Center, says that further OCT applications are being investigated. He and Optovue are developing OCT-based corneal power measurements to improve cataract surgery nomograms. It would take into account both the anterior and posterior corneal curvature, Dr. Huang says. "You can do that with slit scanning Scheimfplug cameras, but their resolution is lower than OCT and the speed is relatively low as well. It takes a second or two to make the measurements." OCT typically takes only 0.3 seconds to map the cornea, he reports.
Dr. Huang says that in a clinical trial of post-LASIK cataract surgery eyes now underway, the OCT corneal power measurement technique has proved more accurate than the clinical history method or the RGP contact lens over refraction method. "LASIK surgery is very common, and pretty soon these patients are going to be old enough to have cataract surgery," he points out. Precise corneal imaging will be of paramount importance in such cases.
"But Can I Afford It?"
Applicability aside, the economic downturn has left just about everyone, in every profession, gun-shy about spending, no matter how smart a prospective investment might be. As Dr. Barthelow puts it, "I can think of 10 good reasons never to let go of a dime!" I heard this while watching the TV show ‘Sponge Bob’ with my kids. This is a principle I live by running my office. You can't just practice medicine anymore; you have to be a business person, too. I don't want to let go of a dime unless it's necessary to run my practice, improves my efficiency or generates income. OCT does."

|
|
FD-OCT provides highly detailed images of anterior (left) and posterior (right) structures. RTVue scans courtesy of David Huang, M.D.
Manufacturers of OCT devices can help an ophthalmologist work out the cost-benefit analysis to see if it makes sound business sense. One company representative we spoke with urges physicians to start with a look at their own patients' demographics: Check how many patients are seen per day and what percentage are Medicare or managed care. Do a random chart review to see what percentage of patients could benefit from an OCT examination, such as glaucoma patients, glaucoma suspects and confirmed AMD patients. Such patients represent justifiable uses of OCT. Usually, the numbers work out so that the doctor will at least cover the monthly lease cost; many can exceed it substantially and generate positive cash flow right away.
For example, if two patients per day were eligible for an OCT exam and a practice sees patients 22 days out of each month, that generates 44 eligible patients per month. The Medicare allowable reimbursement is $42.20 on a national level for a unilateral exam or $84.40 for a bilateral exam, according to Suzanne L. Corcoran, vice president of Corcoran Consulting Group. Multiply that $84.40 by the 44 patients and OCT brings the practice approximately $3,713 per month, or $44,563 annually.
Whether as a lease or a purchase, OCT can quickly turn a profit. Purchased equipment typically generates a significant tax write-off; discuss various scenarios with your tax accountant to see which makes the most sense. Lastly, because OCT is easily performed by technicians, its use isn't dependent upon the surgeon's time and hectic schedule.

Doctors who have incorporated OCT into their practices agree that it quickly pays for itself. Dr. Korenfeld purchased a Stratus OCT from Carl Zeiss Meditec 5 years ago, and he reports that he recouped his investment in just 6 months. Dr. Barthelow says that by performing 5 to 10 OCTs per day, at current reimbursement levels he will be able to pay off his system within a year of purchase. "Everything after that will be just generating income," he says. "And performing OCT takes only about 5 minutes of tech time and an extra couple of minutes of billing time for my biller. Then it takes me about 5 minutes to review the results with the patient."
Dr. Paden made a considerable investment in OCT, purchasing the Spectralis HRA+OCT and building an additional room onto his practice to house it in January 2008. He estimates that his practice spent approximately $300,000 to incorporate OCT and the office expansion. Even with the sizable investment, he says that performing OCT imaging, intravitreal injections and fluorescein angiography covered his costs in 18 months. However, Dr. Paden points out that his practice is located in an area with a high concentration of retirees, and so it is "pathology rich."
Patient Retention — And Addition!
OCT also helps keep your practice profitable by enabling you to provide procedures that physicians previously had to refer to specialists. Dr. Barthelow says by being able to give patients intravitreal injections, he can keep more patients under his care.
"I feel very comfortable now about managing my own macular degeneration and postop CME patients because I have a way to follow them now," he explains. "That generates extra visits and procedure codes that you can calculate into your return on investment as well. Before I had OCT, I was sending a lot of people out to our retinal doctors for evaluation and treatment because I had no way to image the retina. I can keep a lot of those patients in-house now."
Dr. Paden's experience has been similar. "I've expanded my services from all the stuff that I did before to full-service medical retina with intravitreal injections for wet AMD," he says. "Two of my patients have gone to local TV news stations and dragged the newspeople into my office to do features on this new technology, the quality of the pictures and the response in wet AMD treatment. So there's great community awareness from this system."
Not every general ophthalmologist will want or need to add OCT, but those who do can broaden their scope of practice substantially. "There's going to be a lot more retinal pathology and glaucoma as the Baby Boomers continue to get older," says Dr. Barthelow. "They are a very savvy group of patients with higher expectations, and you can really impress them with this type of technology." OM
| Recent OCT Advances |
|---|
| Few devices in ophthalmology have evolved quite as rapidly as OCT of late. Device manufacturers are in an arms race of sorts to outdo each other in image resolution, scanning speed, eye tracking and registration, onboard software for visualization and analysis, integration with EMR systems and many other useful features. Recent advances include the following: • Carl Zeiss Meditec recently upgraded its Cirrus HD-OCT software. Version 4.0 can track changes in glaucoma and retinal disease, and offers support for cataract and refractive surgeons including anterior segment imaging of the cornea and angle, and central cornea thickness measurement for glaucoma management without the need for external lenses. The software compares retinal nerve fiber layer (RNFL) and macular thickness measurements against normative databases to allow physicians to identify pre-existing glaucoma and retinal disease, and offers a battery of statistical analysis measures to assess the clinical significance of RNFL or macular changes over time. • Heidelberg's Spectralis platform now can include up to six imaging modes (fluorescein angiography, ICG angiography, autofluorescence, red-free, infrared and spectral-domain OCT). The system also includes RNFL change analysis software plus the capability of measuring peripapillary atrophy and other anatomic changes. Heidelberg says that its device recently demonstrated reproducibility of 1 micron, the smallest change in a comparative study of six OCT instruments. • Bioptigen offers a handheld SD-OCT device particularly adept at capturing pediatric images. Its portability means that it can go from the clinic to the operating room, and also enables OCT images to be obtained regardless of patient posture. Bioptigen's handheld OCT can acquire and display high-resolution B-scans at 17 fps, the company says. A wide array of add-on probes and scanners are available for greater flexibility. • Optovue's RTVue was the first Fourier-domain OCT on the market and the first to include normative databases for glaucoma and retinal analysis. David Huang, M.D., Ph.D., who has financial interests with Optovue, reports that special disease-specific applications, such as ganglion cell analysis for glaucoma, are available on the RTVue, and more are being developed. A cornea and anterior segment imaging module is available, with software to dewarp the images and map corneal thickness. Corneal power and keratoconus diagnosis software are on the way, according to Dr. Huang. • Topcon's newest version of its TrueMap software for the 3D OCT-1000 features an automatic alignment function that removes artifacts caused by axial eye movement, the company says. The measurement software provides visualization of four layers of the retina and can import Stratus time-domain OCT data. The device also comes with EyeRoute software, Topcon's image management system that allows viewing of 3D images in real time and integrates images and reports from various ophthalmic instruments into a single database. It's the only system to also include a nonmydriatic camera, Topcon says. • Opko/OTI's Spectral OCT/SLO combines optical coherence tomography with a scanning laser ophthalmoscope, and allows anterior segment scans with an optional add-on lens. The device can also capture "microperimetry" data that can be overlaid onto OCT or SLO scans to correlate objective and subjective findings. Images are captured at resolutions of 5 to 6 microns and can be viewed in several different modes onscreen; software aids analysis of change over time. • Canon's SPOCT-HR, licensed from Optopol, is expected to receive FDA approval later this year. The company says it will offer 3-micron resolution, an ultrahigh scanning speed (up to 52,000 A-scans per second), and software packages for glaucoma as well as retinal disease. • Tomey offers an anterior segment OCT system that uses swept-source OCT, also called optical frequency domain imaging. It is an alternative implementation of Fourier Domain-OCT in which the wavelength of the light source is tuned in rapid cycles. The company says its system provides both high resolution and wide area measurements. It offers a penetration depth of 6 mm. |








